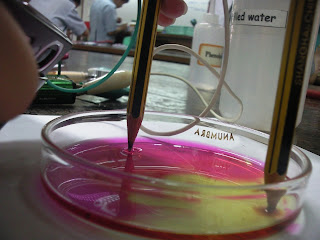

Olevel is nearing and for those who haven't start studying,
please start studying
NOW. There isn't any more time
for us to waste. So
stop going out shopping, watching movie
or even
spending time talking away with friends.
From now till the end of Olevel, the ones that you should be
spending your time with most of the time are your books.
Your best friends should be your darling books now.
Start studying!
You can see very well from our English Block Test results
that we have to work harder, in order to achieve our English
Olevel target which is mostly B3 for the class. Without any
effort put in, do you really think that your grades can jump
to your desired grade?
Think twice.
English Block Test,
only 6 people passed the test.
That is not a very good result for our class.
People, buck up. I know that we can do better.
I mean, the teachers have high expectations for us.
You do want to make them proud, don't you?
Most importantly, we should work all hard towards our
own individual goal, to
make ourself proud.
From this point of time onwards,
for those who haven't start studying. Please start now.
It's already mid July, do not drag any longer.
The clock is ticking away. Time will not wait for you.
With love,Caroline (:




 4E1 pupils are behind but i think he looks cute in this pic ;)isn't he?
4E1 pupils are behind but i think he looks cute in this pic ;)isn't he?
 we went to Mdm.Cheah's house together with literature students to wish her a happy chinese new year..only a few pictures were taken but we enjoyed exchanging of oranges very much :D
we went to Mdm.Cheah's house together with literature students to wish her a happy chinese new year..only a few pictures were taken but we enjoyed exchanging of oranges very much :D